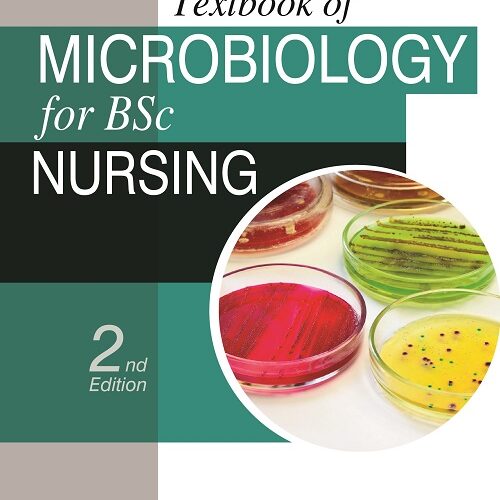
Textbook of Microbiology for BSc Nursing by Surinder Kumar

NURSING
“HEINE Classic+ Miller Pediatric Fiber Optic Laryngoscope Blade – F-000.22.122 (SIZE 2)” has been added to your cart. View cart
-
Sale!

-
Sale!

MSc Nursing Log Book by I Clement
₹325.00Original price was: ₹325.00.₹276.25Current price is: ₹276.25. excl. gst -
Sale!

Nursing Foundation-Concepts and Perspectives (For Post Basic BSc Nursing) by Jogindra Vati
₹795.00Original price was: ₹795.00.₹675.75Current price is: ₹675.75. excl. gst -
Sale!

Textbook of Communication and Education Technology for Nurses By KP NEERAJA
₹995.00Original price was: ₹995.00.₹845.75Current price is: ₹845.75. excl. gst -
Sale!

Nursing Solved Question Papers for BSc Nursing 1st Year (2022-2017) by I Clement
₹925.00Original price was: ₹925.00.₹786.25Current price is: ₹786.25. excl. gst -
Sale!

Nursing Administration by Basavanthappa Bt
₹1,995.00Original price was: ₹1,995.00.₹1,655.85Current price is: ₹1,655.85. excl. gst -
Sale!

Maternal and Neonatal Nursing Care Plans by Annamma Jacob
₹1,450.00Original price was: ₹1,450.00.₹1,232.50Current price is: ₹1,232.50. excl. gst -
Sale!

Dictionary of Nurses by Vishal Tak (English-Hindi)
₹595.00Original price was: ₹595.00.₹505.75Current price is: ₹505.75. excl. gst -
Sale!
Textbook of Microbiology for BSc Nursing by SURINDER KUMAR
₹625.00Original price was: ₹625.00.₹531.25Current price is: ₹531.25. excl. gst -
Sale!

Practical Record Book for Psychiatric/Mental Health Nursing by Beck Ellen
₹425.00Original price was: ₹425.00.₹361.25Current price is: ₹361.25. excl. gst -
Sale!

Applied Sociology and Psychology for Nurses by Shiv Shankar Tyagi
₹650.00Original price was: ₹650.00.₹552.50Current price is: ₹552.50. excl. gst -
Sale!

Anthikad’s Applied Psychology for Graduate Nurses (General and Educational Psychology) by Deepa Marina Rasquinha
₹595.00Original price was: ₹595.00.₹505.75Current price is: ₹505.75. excl. gst -
Sale!

Comprehensive Textbook on Foundations of Nursing-II – Essential Guide for Nursing Students By REBECCA NISSANKA (JADHAV)
₹1,395.00Original price was: ₹1,395.00.₹722.50Current price is: ₹722.50. excl. gst -
Sale!

Fundamentals of Nursing by Basavanthappa
₹1,995.00Original price was: ₹1,995.00.₹1,655.85Current price is: ₹1,655.85. excl. gst -
Sale!

Practical Manual for Final Year Exam Preparation – GEMS: A Golden Endeavor for Medical Students By ALI M LIYAKKATH
₹1,095.00Original price was: ₹1,095.00.₹1,018.35Current price is: ₹1,018.35. excl. gst -
Sale!

Textbook of Physiology for Nursing Students – Comprehensive Guide to Core Concepts By N GEETHA
₹950.00Original price was: ₹950.00.₹807.50Current price is: ₹807.50. excl. gst

HEINE Classic+ Miller Pediatric Fiber Optic Laryngoscope Blade - F-000.22.122 (SIZE 2)